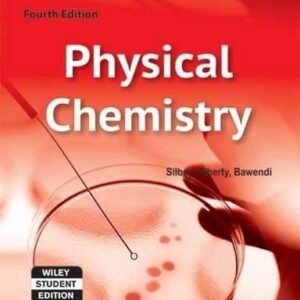
9788126508778.jpg

Uncategorized
Showing 1297–1312 of 2129 results
-

Perks Of Being A Wallflower
350.00د.إ Add to cart -

Perl: The Complete Reference
895.00د.إ Add to cart -

Personal Trainer: Pilates & Yoga
395.00د.إ Add to cart -

Personal Trainer: Yoga For Life
395.00د.إ Add to cart -

Personality Development
850.00د.إ Add to cart -

Personality Management
150.00د.إ Add to cart -

Personnel Management
545.00د.إ Add to cart -

Philosophy Of Science: Teach Yourself
699.00د.إ Add to cart -

Photonics And Quantum Structures 172Pp/Hb
450.00د.إ Add to cart -

Physical Chemistry Of Macromolecules
995.00د.إ Add to cart -

Physical Chemistry, 4Th Ed
659.00د.إ Add to cart -

Physics & Philosophy
200.00د.إ Add to cart -

Physics Of Semiconductor Devices, 3Rd Ed
539.00د.إ Add to cart -

Picnic Meals
59.00د.إ Add to cart -

Picture Of Dorian Gray & Other Writing
150.00د.إ Add to cart -

Pink Slippers: Mia And The Too Big Tutu (Oct-10)
199.00د.إ Add to cart